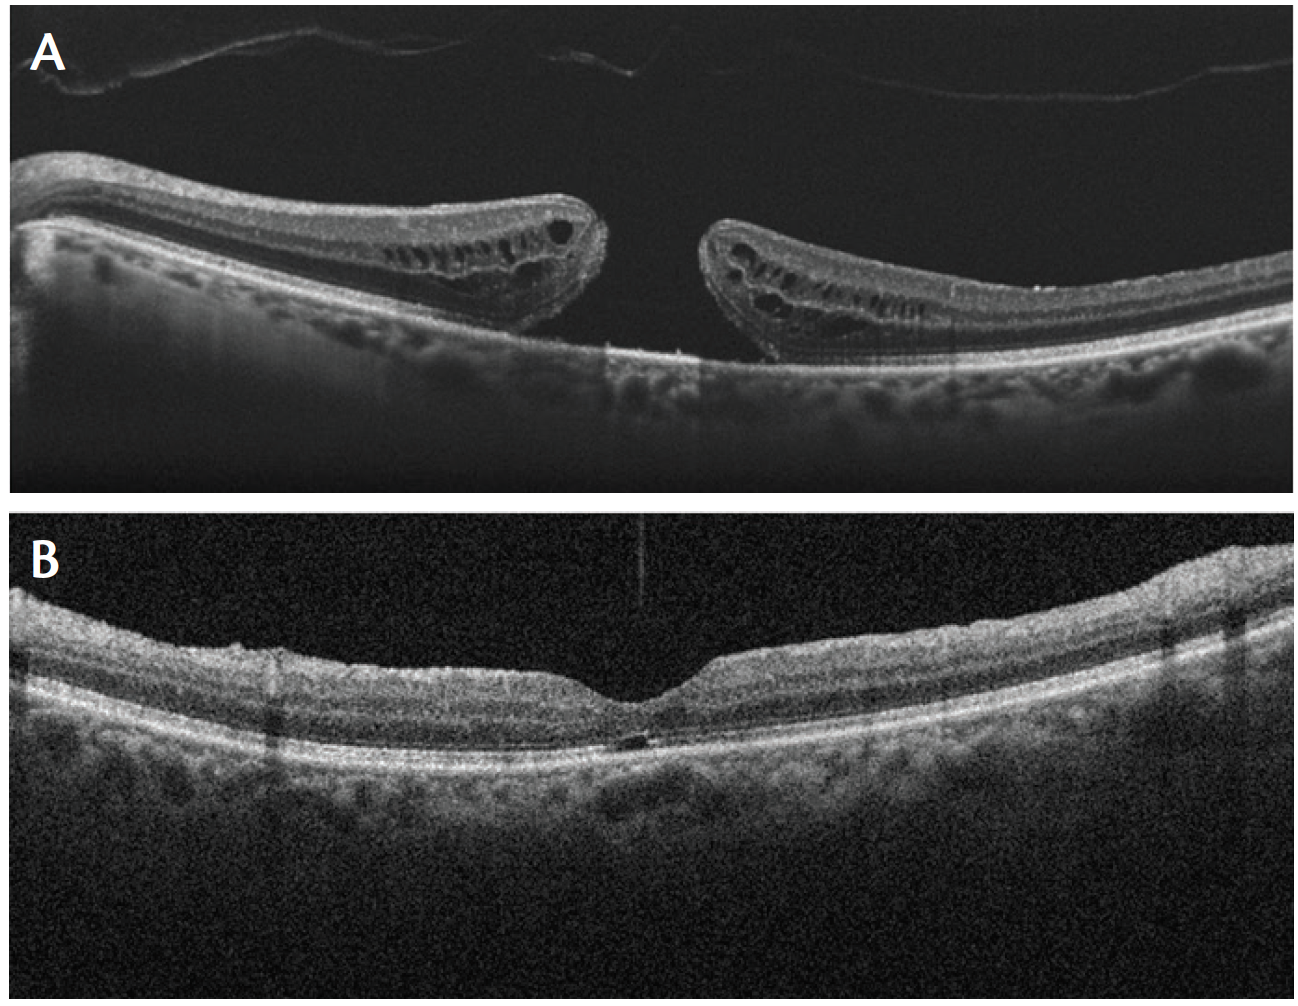
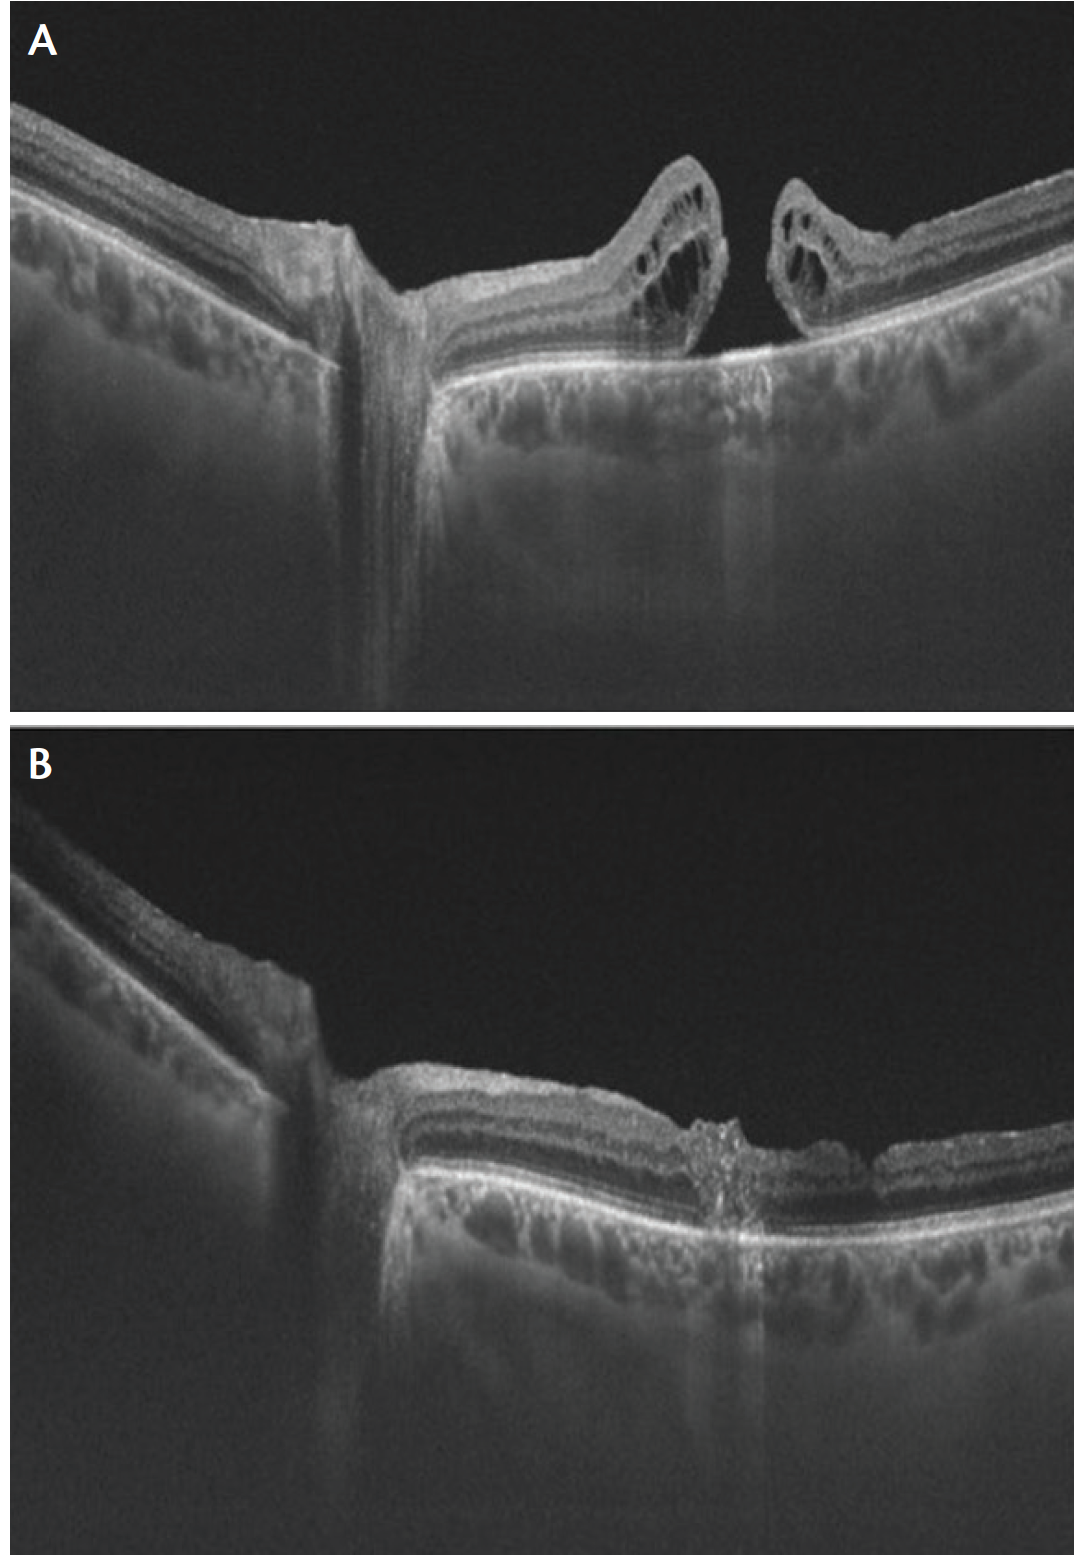

The inverted internal limiting membrane (ILM) flap technique, first described by Michalewska et al in 2010, is an effective surgical technique for treating large idiopathic full thickness macular holes (MHs) and myopic MHs.1 These authors reported that the innovative technique increased their rate of complete MH closure to 98% for large idiopathic MHs (diameter exceeding 400 mm), compared with an 88% closure rate with conventional vitrectomy and ILM peeling. This excellent anatomic result was associated with significant functional improvement in visual acuity, and the postoperative flat, open appearance of MHs was not observed.
THE TECHNIQUE AND THE SCIENCE
In the inverted ILM flap technique, after core vitrectomy and dye staining, the ILM is not completely removed from the retina but is left in place, attached to the edges of the MH. This ILM remnant is then inverted to cover and fill the MH. Finally, fluid-air exchange is performed.
AT A GLANCE
• The authors have found the inverted ILM flap technique to be a safe and successful procedure for treating large idiopathic full thickness MHs and myopic MHs.
• After core vitrectomy and dye staining, the technique consists of leaving a remnant of the ILM in place attached to the edges of the MH. The ILM remnant is inverted to cover and fill the MH and then fluid-air exchange is performed.
• The use of an inverted ILM flap over the MH seems to be more effective than complete ILM peeling in cases of myopic MH with retinal detachment.
Several mechanisms have been proposed to explain the tissue repair that occurs following use of the inverted ILM flap technique. The inverted ILM, containing Müller cell fragments, may induce glial cell proliferation, filling the MH and supporting MH closure. It may also work as a scaffold for tissue proliferation, creating a microenvironment that encourages correct photoreceptor positioning and finally improving postoperative anatomic and functional outcome. This hypothesis is in agreement with histopathologic findings suggesting that a basement membrane is required for cell proliferation. Because ILM is a basement membrane, it allows glial cell proliferation, and large MHs fill with tissue over time.
EARLY EXPERIENCE
Many authors have since reported similar satisfactory results with the inverted flap technique for treating large idiopatic MHs, further expanding its use to myopic MH and repeat MH surgery.2,3 Michalewska et al also confirmed similar encouraging results in the treatment of myopic MH without retinal detachment.4 They reported that the rate of complete closure was 100% for high-myopic MHs, and they confirmed that the process of foveal architectural repair after the surgery continued over at least a 12-month period. This technique allowed not only a high closure rate in myopic MHs, but also a functional improvement in visual acuity.
A recent study compared the results of vitrectomy plus complete ILM removal with the results of the inverted ILM flap technique in the treatment of myopic MH without retinal detachment.5 The functional and anatomic outcomes reported with the inverted ILM flap technique were superior to those with complete ILM removal for the treatment of myopic MH.
Figure 1. Example of large full thickness MH closure after classic ILM flap technique. Full thickness MH open before surgery (A) and closed 3 months postoperatively, with restoration of foveal architecture and persistence of small ellipsoid zone defect (B).
Other authors have compared the inverted flap technique to ILM removal for myopic MH with retinal detachment.6 They reported anatomic and functional improvement when the inverted ILM flap was inserted into the myopic MH. The use of an inverted ILM flap over the MH seems to be more effective than complete ILM peeling in these challenging cases.
Variants of the classic inverted flap technique have been described, including autologous extramacular retinal free flap autotransplantation for reoperation cases in which there is no ILM bordering the MH.7
To minimize iatrogenic trauma associated with ILM peeling, Michalewska et al introduced a modified procedure in which ILM is peeled from the temporal side of the fovea only. They found that this temporal inverted ILM flap technique was as effective as the classic inverted ILM flap technique for the repair of large MHs.8
PERSONAL EXPERIENCE
In our own experience, the inverted ILM flap technique appears to be a safe and successful procedure for the management of large idiopathic MHs and myopic MHs. We have treated patients with idiopathic large MHs (diameter 400mm) and with large myopic MHs (diameter 400 mm) using pars plana vitrectomy and the inverted ILM flap technique. Swept-source optical coherence tomography (OCT), spectral-domain OCT, OCT angiography, and adaptive optics images were used to assess the anatomic outcomes of surgery, and BCVA and microperimetry were used to evaluate the functional outcomes during 6 months of follow-up.
MH closure was observed in 97.5% of patients after one procedure. On OCT images, the healing process showed the appearance of a hyperreflective material filling the MH; gradually, this material contracted, inducing MH closure. All patients showed improvement in visual function, both in BCVA and multifocal electroretinography responses, during the first 3 months after surgery.
Figure 2. Example of full thickness MH closure after ILM autotransplant. Full thickness MH open before surgery (A) and closed 3 months postoperatively (B). A glial plug filling the MH is visible.
We observed different OCT findings after the classic ILM flap technique and ILM autotransplantation: In the former, we could see restoration of normal foveal architecture during follow-up (Figure 1); in the latter, we observed the persistence of a glial plug during follow-up (Figure 2). We have hypothesized that there are two different mechanisms of MH closure with the two techniques. After the classic inverted flap technique, the ILM acts like a scaffold for tissue proliferation, producing an environment for the photoreceptors to assume new positions in direct proximity to the fovea, and perfect anatomic restoration takes place. After ILM autotransplant, by contrast, the glial plug remains visible during follow-up.
CONCLUSION
Vitrectomy with the inverted ILM flap technique seems to be a safe and effective surgery for idiopathic and myopic large MHs, improving both functional and anatomic outcomes. Postoperative evaluation with new retinal imaging techniques including structural OCT, OCT angiography, and adaptive optics, and with functional tests such as microperimetry, may help to elucidate the structural and functional changes associated with this surgical technique and to understand the mechanisms of postoperative improvement observed in the retinal architecture.
1. Michalewska Z, Michalewski J, Adelman RA, Nawrocki J. Inverted internal limiting membrane flap technique for large macular holes. Ophthalmology. 2010;117:2018-2025.
2. Hayashi H, Kuriyama S. Foveal microstructure in macular holes surgically closed by inverted internal limiting membrane flap technique. Retina. 2014;34(12):2444-2450.
3. Olenik A, Rios J, Mateo C. Inverted internal limiting membrane flap technique for macular holes in high myopia with axial length ≥30 mm. Retina. 2016;36(9):1688-1693.
4. Michalewska Z, Michalewski J, Dulczewska-Cichecka K, Nawrocki J. Inverted internal limiting membrane flap technique for surgical repair of myopic macular holes. Retina. 2014;34:664-669.
5. Mete M, Alfano A, Guerriero M, et al. Inverted internal limiting membrane flap technique versus complete internal limiting membrane removal in myopic macular hole surgery: a comparative study [published online ahead of print January 6, 2017]. Retina.
6. Chen SN, Yang CM. Inverted internal limiting membrane insertion for macular hole-associated retinal detachment in high myopia. Am J Ophthalmol. 2016;166:211.
7. Andrew N, Chan WO, Tan M, Ebneter A, Gilhotra JS. Modification of the inverted internal limiting membrane flap technique for the treatment of chronic and large macular holes. Retina. 2016;36(4):834-837.
8. Michalewska Z, Michalewski J, Dulczewska-Cichecka K, Adelman RA, Nawrocki J. Temporal inverted internal limiting membrane flap technique versus classic inverted internal limiting membrane flap technique: a comparative study. Retina. 2015;35(9):1844-1850.
Section Editor Albert Augustin, MD
• professor and chairman of the department of ophthalmology, Staedtisches Klinikum Karlsruhe, in Karlsruhe, Germany
Section Editor Ehab N. El-Rayes, MD, PhD
• professor of ophthalmology, Institute of Ophthalmology in Cairo, Egypt; vitreoretinal consultant, The Retina Clinic, in Cairo, Egypt
Section Editor, Masahito Ohji, MD
• professor and chairman of the department of ophthalmology, Shiga University of Medical Science, in Otsu, Shiga, Japan
Section Editor, Stanislao Rizzo, MD
• associate professor and chairman, department of ophthalmology, University of Florence, Azienda Ospedaliero Universitaria Careggi, Florence, Italy; member of the Retina Today editorial advisory board
• financial interest: none acknowledged
• stanislao.rizzo@gmail.com
Daniela Bacherini, MD
• neuroscience PhD, department of ophthalmology, University of Florence, Azienda Ospedaliero Universitaria Careggi, Florence, Italy
• financial interest: none acknowledged
• daniela.bacherini@gmail.com




















